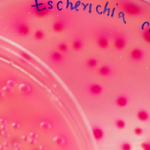

Bergaul dengan Baterai Litium-Ion
Saat ini baterai menjadi barang yang tidak bisa dilepaskan dalam kehidupan kita sehari-hari. HP, digital kamera, laptop, bahkan robot dan mobil, semuanya memerlukan baterai sebagai sumber penggerak. Baterai akan menjadi salah satu sumber energi masa depan yang sangat menjanjikan. Di antara banyak jenis baterai, baterai litium-ion mendapat perhatian utama. Selain memiliki kepadatan energi yang tinggi, […]